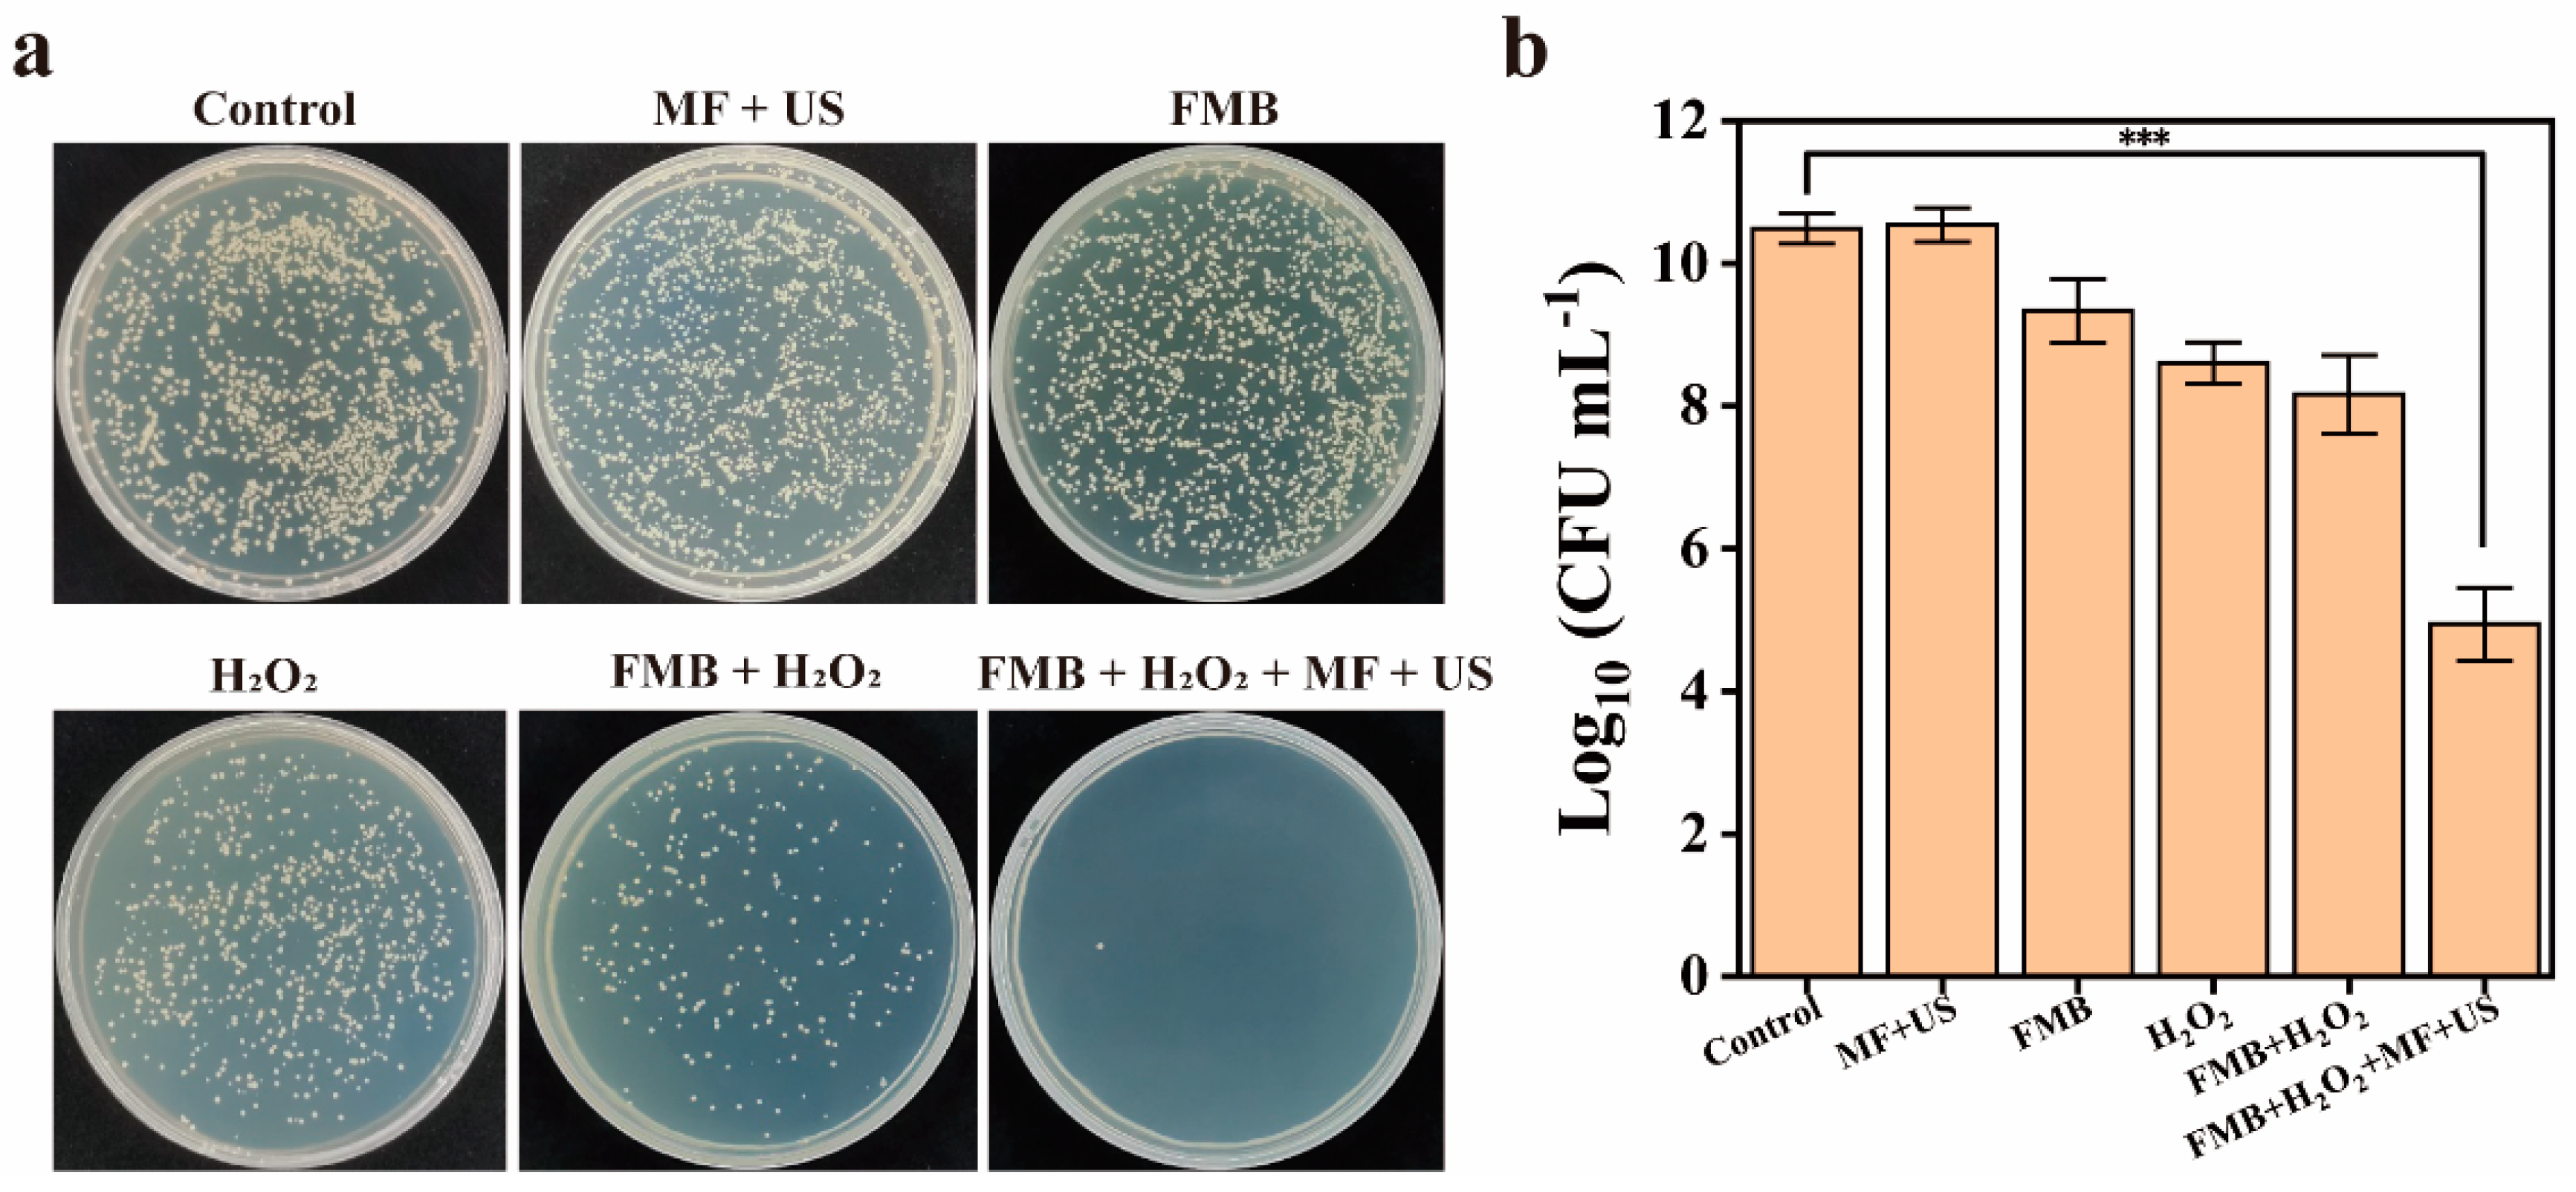
Nanomaterials 14 01830 g008

Magnetic Field/Ultrasound-Responsive Fe3O4 Microbubbles for Targeted Mechanical/Catalytic Removal of Bacterial Biofilms
Abstract
1. Introduction
2. Materials and Methods
2.1. Materials and Reagents
2.2. Preparation of FMB
2.3. MF/US-Responsive Properties of FMB
2.4. Catalytic Effects of FMB
2.5. MF-Targeted Mechanical Disruption of Biofilms
2.6. Mechanical/Catalytic Destruction of MRSA Biofilms
2.7. Antibacterial Effect on MRSA Biofilms
2.8. Fluorescence Imaging of MRSA Biofilms
2.9. Culture of MRSA Biofilms on Catheters
2.10. Removal of MRSA Biofilms from Catheters In Vitro
2.11. Removal of MRSA Biofilms from Catheters In Vivo
2.12. Statistical Analysis
3. Results
3.1. Characterization of FMB
3.2. US and MF Response Performance of FMB
3.3. Catalytic Properties of FMB
3.4. Destruction of MRSA Biofilms by FMB in 96-Well Plates
3.5. Destruction of MRSA Biofilms by FMB in Catheter In Vitro
3.6. Treatment of Catheter MRSA Biofilms Infection by FMB in Mice
3.7. Biosafety of FMB
4. Conclusions
Supplementary Materials
Author Contributions
Funding
Data Availability Statement
Conflicts of Interest
References
- Flemming, H.-C.; Wingender, J. The biofilm matrix. Nat. Rev. Microbiol. 2010, 8, 623–633. [Google Scholar] [CrossRef] [PubMed]
- Hall-Stoodley, L.; Costerton, J.W.; Stoodley, P. Bacterial biofilms: From the natural environment to infectious diseases. Nat. Rev. Microbiol. 2004, 2, 95–108. [Google Scholar] [CrossRef]
- Flemming, H.-C.; Wingender, J.; Szewzyk, U.; Steinberg, P.; Rice, S.A.; Kjelleberg, S. Biofilms: An Emergent Form of Bacterial Life. Nat. Rev. Microbiol. 2016, 14, 563–575. [Google Scholar] [CrossRef] [PubMed]
- Fleming, D.; Chahin, L.; Rumbaugh, K. Glycoside Hydrolases Degrade Polymicrobial Bacterial Biofilms in Wounds. Antimicrob. Agents Chemother. 2017, 61, e01998-16. [Google Scholar] [CrossRef]
- Singh, A.; Amod, A.; Pandey, P.; Bose, P.; Pingali, M.S.; Shivalkar, S.; Varadwaj, P.K.; Sahoo, A.K.; Samanta, S.K. Bacterial Biofilm Infections, Their Resistance to Antibiotics Therapy and Current Treatment Strategies. Biomed. Mater. 2022, 17, 022003. [Google Scholar] [CrossRef] [PubMed]
- Daddi Oubekka, S.; Briandet, R.; Fontaine-Aupart, M.-P.; Steenkeste, K. Correlative Time-Resolved Fluorescence Microscopy To Assess Antibiotic Diffusion-Reaction in Biofilms. Antimicrob. Agents Chemother. 2012, 56, 3349–3358. [Google Scholar] [CrossRef]
- Zhao, A.; Sun, J.; Liu, Y. Understanding Bacterial Biofilms: From Definition to Treatment Strategies. Front. Cell Infect. Microbiol. 2023, 13, 1137947. [Google Scholar] [CrossRef]
- LuTheryn, G.; Glynne-Jones, P.; Webb, J.S.; Carugo, D. Ultrasound-mediated Therapies for the Treatment of Biofilms in Chronic Wounds: A Review of Present Knowledge. Microb. Biotechnol. 2020, 13, 613–628. [Google Scholar] [CrossRef]
- Høiby, N.; Bjarnsholt, T.; Moser, C.; Bassi, G.L.; Coenye, T.; Donelli, G.; Hall-Stoodley, L.; Holá, V.; Imbert, C.; Kirketerp-Møller, K.; et al. ESCMID* Guideline for the Diagnosis and Treatment of Biofilm Infections 2014. Clin. Microbiol. Infect. 2014, 21, S1–S25. [Google Scholar] [CrossRef]
- Hwang, G.; Paula, A.J.; Hunter, E.E.; Liu, Y.; Babeer, A.; Karabucak, B.; Stebe, K.; Kumar, V.; Steager, E.; Koo, H. Catalytic Antimicrobial Robots for Biofilm Eradication. Sci. Robot. 2019, 4, eaaw2388. [Google Scholar] [CrossRef]
- Zhou, D.; Zhang, Z.; Qiu, B.; Zhang, D.; Xie, S.; Huang, K.; Li, X. Ultrasound-Activated Persistent Luminescence Imaging and Bacteria-Triggered Drug Release for Helicobacter Pylori Infection Theranostics. ACS Appl. Mater. Interfaces. 2022, 14, 26418–26430. [Google Scholar] [CrossRef]
- Jia, B.; Du, X.; Wang, W.; Qu, Y.; Liu, X.; Zhao, M.; Li, W.; Li, Y. Nanophysical Antimicrobial Strategies: A Rational Deployment of Nanomaterials and Physical Stimulations in Combating Bacterial Infections. Adv. Sci. 2022, 9, 2105252. [Google Scholar] [CrossRef]
- Quan, K.; Zhang, Z.; Chen, H.; Ren, X.; Ren, Y.; Peterson, B.W.; Van Der Mei, H.C.; Busscher, H.J. Artificial Channels in an Infectious Biofilm Created by Magnetic Nanoparticles Enhanced Bacterial Killing by Antibiotics. Small 2019, 15, 1902313. [Google Scholar] [CrossRef]
- Mayorga-Martinez, C.C.; Zelenka, J.; Klima, K.; Mayorga-Burrezo, P.; Hoang, L.; Ruml, T.; Pumera, M. Swarming Magnetic Photoactive Microrobots for Dental Implant Biofilm Eradication. ACS Nano 2022, 16, 8694–8703. [Google Scholar] [CrossRef]
- Xu, C.; Pu, K. Second Near-Infrared Photothermal Materials for Combinational Nanotheranostics. Chem. Soc. Rev. 2021, 50, 1111–1137. [Google Scholar] [CrossRef]
- Ganesh, K.; Sinha, M.; Mathew-Steiner, S.S.; Das, A.; Roy, S.; Sen, C.K. Chronic Wound Biofilm Model. Adv. Wound Care 2015, 4, 382–388. [Google Scholar] [CrossRef]
- Diban, F.; Lodovico, S.D.; Fermo, P.D.; D’Ercole, S.; D’Arcangelo, S.; Giulio, M.D.; Cellini, L. Biofilms in Chronic Wound Infections: Innovative Antimicrobial Approaches Using the In Vitro Lubbock Chronic Wound Biofilm Model. Int. J. Mol. Sci. 2023, 24, 1004. [Google Scholar] [CrossRef]
- Wang, X.; Li, J.; Zhang, S.; Zhou, W.; Zhang, L.; Huang, X. pH-Activated Antibiofilm Strategies for Controlling Dental Caries. Front. Cell Infect. Microbiol. 2023, 13, 1130506. [Google Scholar] [CrossRef]
- Xiu, W.; Ren, L.; Xiao, H.; Zhang, Y.; Wang, D.; Yang, K.; Wang, S.; Yuwen, L.; Li, X.; Dong, H.; et al. Ultrasound-Responsive Catalytic Microbubbles Enhance Biofilm Elimination and Immune Activation to Treat Chronic Lung Infections. Sci. Adv. 2023, 9, eade5446. [Google Scholar] [CrossRef]
- Liang, M.; Wang, Y.; Ma, K.; Yu, S.; Chen, Y.; Deng, Z.; Liu, Y.; Wang, F. Engineering Inorganic Nanoflares with Elaborate Enzymatic Specificity and Efficiency for Versatile Biofilm Eradication. Small 2020, 16, 2002348. [Google Scholar] [CrossRef]
- Naha, P.C.; Liu, Y.; Hwang, G.; Huang, Y.; Gubara, S.; Jonnakuti, V.; Simon-Soro, A.; Kim, D.; Gao, L.; Koo, H.; et al. Dextran-Coated Iron Oxide Nanoparticles as Biomimetic Catalysts for Localized and pH-Activated Biofilm Disruption. ACS Nano 2019, 13, 4960–4971. [Google Scholar] [CrossRef] [PubMed]
- Xiu, W.; Shan, J.; Wang, L.; Yang, K.; Xiao, H.; Yuwen, L. Recent Development of Nanomedicine for the Treatment of Bacterial Biofilm Infections. View 2021, 2, 20200065. [Google Scholar] [CrossRef]
- Dong, Y.; Wang, L.; Yuan, K.; Ji, F.; Gao, J.; Zhang, Z.; Du, X.; Tian, Y.; Wang, Q.; Zhang, L. Magnetic Microswarm Composed of Porous Nanocatalysts for Targeted Elimination of Biofilm Occlusion. ACS Nano 2021, 15, 5056–5067. [Google Scholar] [CrossRef]
- Gao, L.; Liu, Y.; Kim, D.; Li, Y.; Hwang, G.; Naha, P.C.; Cormode, D.P.; Koo, H. Nanocatalysts Promote Streptococcus Mutans Biofilm Matrix Degradation and Enhance Bacterial Killing to Suppress Dental Caries in Vivo. Biomaterials 2016, 101, 272–284. [Google Scholar] [CrossRef] [PubMed]

Disclaimer/Publisher’s Note: The statements, opinions and data contained in all publications are solely those of the individual author(s) and contributor(s) and not of MDPI and/or the editor(s). MDPI and/or the editor(s) disclaim responsibility for any injury to people or property resulting from any ideas, methods, instructions or products referred to in the content. |
© 2024 by the authors. Licensee MDPI, Basel, Switzerland. This article is an open access article distributed under the terms and conditions of the Creative Commons Attribution (CC BY) license (https://creativecommons.org/licenses/by/4.0/).
Share and Cite
Lu, L.; Liu, Y.; Chen, X.; Xu, F.; Zhang, Q.; Yin, Z.; Yuwen, L. Magnetic Field/Ultrasound-Responsive Fe3O4 Microbubbles for Targeted Mechanical/Catalytic Removal of Bacterial Biofilms. Nanomaterials 2024, 14, 1830. https://doi.org/10.3390/nano14221830
Lu L, Liu Y, Chen X, Xu F, Zhang Q, Yin Z, Yuwen L. Magnetic Field/Ultrasound-Responsive Fe3O4 Microbubbles for Targeted Mechanical/Catalytic Removal of Bacterial Biofilms. Nanomaterials. 2024; 14(22):1830. https://doi.org/10.3390/nano14221830
Chicago/Turabian StyleLu, Liang, Yuan Liu, Xiaolong Chen, Fengjiao Xu, Qi Zhang, Zhaowei Yin, and Lihui Yuwen. 2024. "Magnetic Field/Ultrasound-Responsive Fe3O4 Microbubbles for Targeted Mechanical/Catalytic Removal of Bacterial Biofilms" Nanomaterials 14, no. 22: 1830. https://doi.org/10.3390/nano14221830
APA StyleLu, L., Liu, Y., Chen, X., Xu, F., Zhang, Q., Yin, Z., & Yuwen, L. (2024). Magnetic Field/Ultrasound-Responsive Fe3O4 Microbubbles for Targeted Mechanical/Catalytic Removal of Bacterial Biofilms. Nanomaterials, 14(22), 1830. https://doi.org/10.3390/nano14221830

